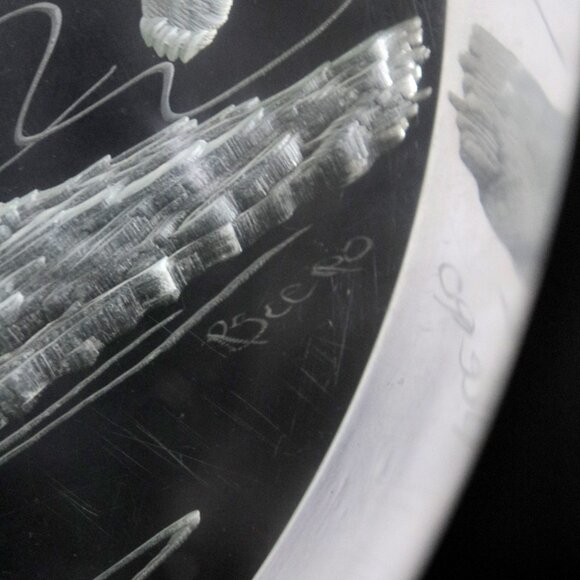

Vintage Signed Carved Lucite Polar Bear Scene Sculpture, Arctic Northern Art
C$48
Size
Like and save for later
Add To Bundle
A beautiful etched clear plastic sculpture featuring a wintery arctic scene. Signed but I can't quite read the name. Not sure if the plastic is acrylic or lucite.
[ YEAR ] 1980s
[ BRAND ] n/a
[ CONDITION ] great
• light scuffs on the surfaces consistent with age
• plastic has yellowed ever so slightly
[ DIMENSIONS ] see photo with ruler in metric & imperial units
Shipping/Discount
Trending Now
Find Similar Listings
Account is under Review
Comment posting is temporarily restricted. Our team will reach out to you shortly. To understand why, select
Learn More.